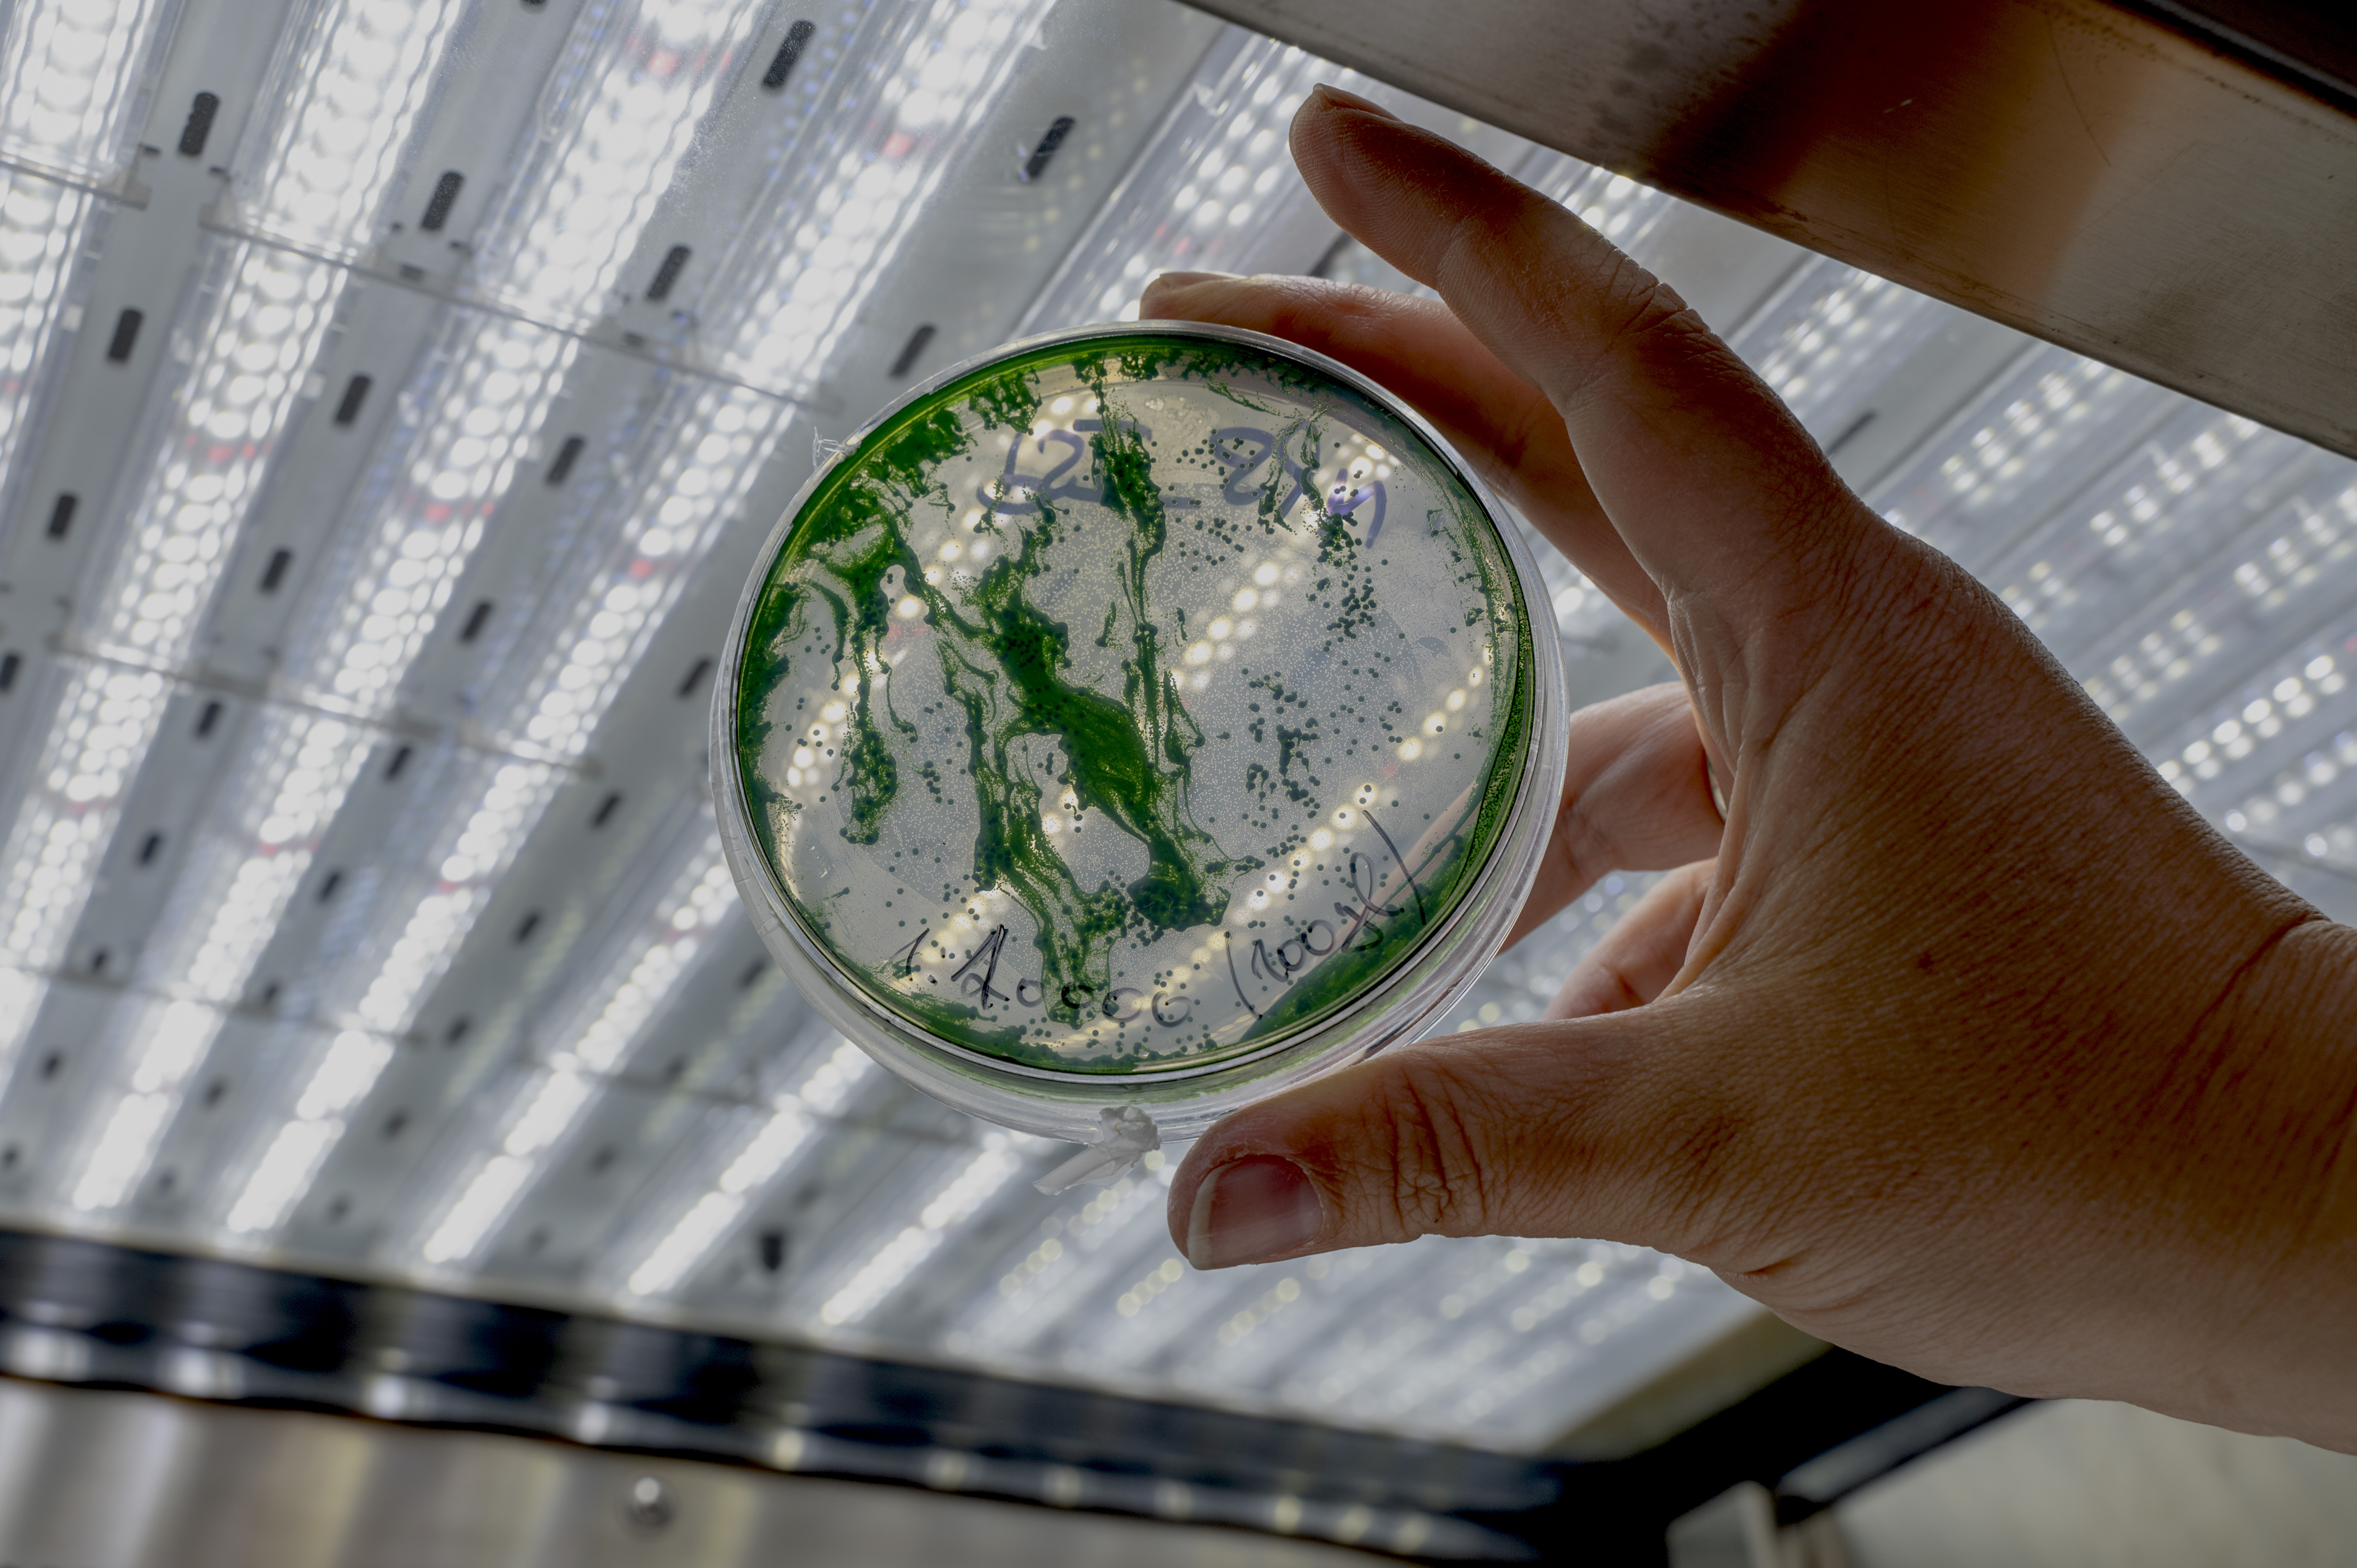

Обзор
Инкубаторы серии AlgaeTron AG 160/AG 300 предназначены для высококачественного культивирования водорослей, цианобактерий и растительных тканей в лабораторных условиях. Они подходят для размещения различных культур в чашках Петри, многолуночных планшетах и колбах Эрленмейера. Использование передовых светодиодных технологий обеспечивает высокую интенсивность освещения и минимальное выделение тепла.
Особенности и преимущества
Компактный и просторный дизайн:
- AG 160: две полки, подходит для небольших лабораторий.
- AG 300: четыре независимые регулируемые полки, идеален для масштабных исследований.
Интуитивное управление:
- Сенсорный экран 7 дюймов с удобным интерфейсом.
- Возможность программирования режимов освещения, температуры и дневных циклов.
Продвинутое LED-освещение:
- Независимая регулировка белых и дальних красных светодиодов.
- Максимальная интенсивность освещения до 500 µmol·m⁻²·s⁻¹ (с возможностью увеличения до 1500 µmol·m⁻²·s⁻¹).
Оптимальные условия культивирования:
- Встроенный воздушный насос и порты для аэрации на каждой полке.
- Возможность оснащения полок шейкерами для перемешивания жидких культур.
- Внутренняя отделка из нержавеющей стали обеспечивает стерильные условия и однородность среды.
Надежность и экологичность:
- Прочный корпус из оцинкованной стали.
- Использование экологически безопасного хладагента R290.
Технические характеристики
| Параметры | AlgaeTron AG 160 | AlgaeTron AG 300 |
|---|---|---|
| Объем | 163 л | 307 л |
| Освещаемые уровни | 2 | 4 |
| Размеры полок (Ш×Г) | 48,5 × 38,5 см | 48,5 × 38,5 см |
| Общая площадь выращивания | 0,38 м² | 0,75 м² |
| Температурный диапазон | 10 – 45 °C | 10 – 45 °C |
| Внутренние размеры (Ш×Г×В) | 51 × 45 × 71 см | 51 × 45 × 135 см |
| Внешние размеры (Ш×Г×В) | 60 × 62 × 114 см | 60 × 62 × 177 см |
| Подача воздуха | 150 л/час | 150 л/час |
Характеристики LED-освещения
- Верхняя панель: белые светодиоды + дальний красный (735 нм).
- Нижняя панель: белые светодиоды + дальний красный (735 нм).
Максимальная интенсивность освещения (PPFD на расстоянии 30 см):
- Верхняя панель:
- Стандарт: 500 µmol·m⁻²·s⁻¹
- Опционально: 1500 µmol·m⁻²·s⁻¹
- Нижняя панель:
- Стандарт: 350 µmol·m⁻²·s⁻¹
- Опционально: 500 µmol·m⁻²·s⁻¹
Программное обеспечение
- Сбор и визуализация данных в реальном времени.
- Сенсорный экран (7"), расположенный на передней панели.
- Память на 100 пользовательских программ.
- Графическое отображение текущих и заданных параметров.
Дополнительные аксессуары
Газосмесительная система GMS 150
Система GMS 150 предназначена для точного смешивания до четырех различных газов. Потоки входных газов измеряются термомассовыми расходомерами и регулируются встроенными контроллерами. GMS 150 может использоваться как самостоятельное устройство с локальным управлением, а также позволяет задавать абсолютные или относительные концентрации газов.
Основные особенности GMS 150:
- Поддерживает широкий диапазон расхода газов: от 1 мл/мин до 1000 л/мин.
- Контроль потоков в диапазоне от 2% до 100%.
- Подходит для воздуха, CO₂, азота, NO₂, аммиака и других газов.
- Максимальный суммарный поток: стандартная лабораторная версия до 2 л/мин, крупномасштабная версия до 20 л/мин.
- Новая версия GMS 150-MICRO предназначена для более низких расходов (10 мл/мин – 2,5 л/мин).
Технические требования:
- Источник CO₂ или другого газа.
- Сухой, безмасляный воздух под давлением 3–5 бар с фильтром.
Обслуживание:
- Регулярная проверка и калибровка системы рекомендована каждые 2 года.
Применение:
- Исследования и промышленность.
- Биотехнология водорослей.
- Подготовка газовых смесей для аналитических и производственных задач.